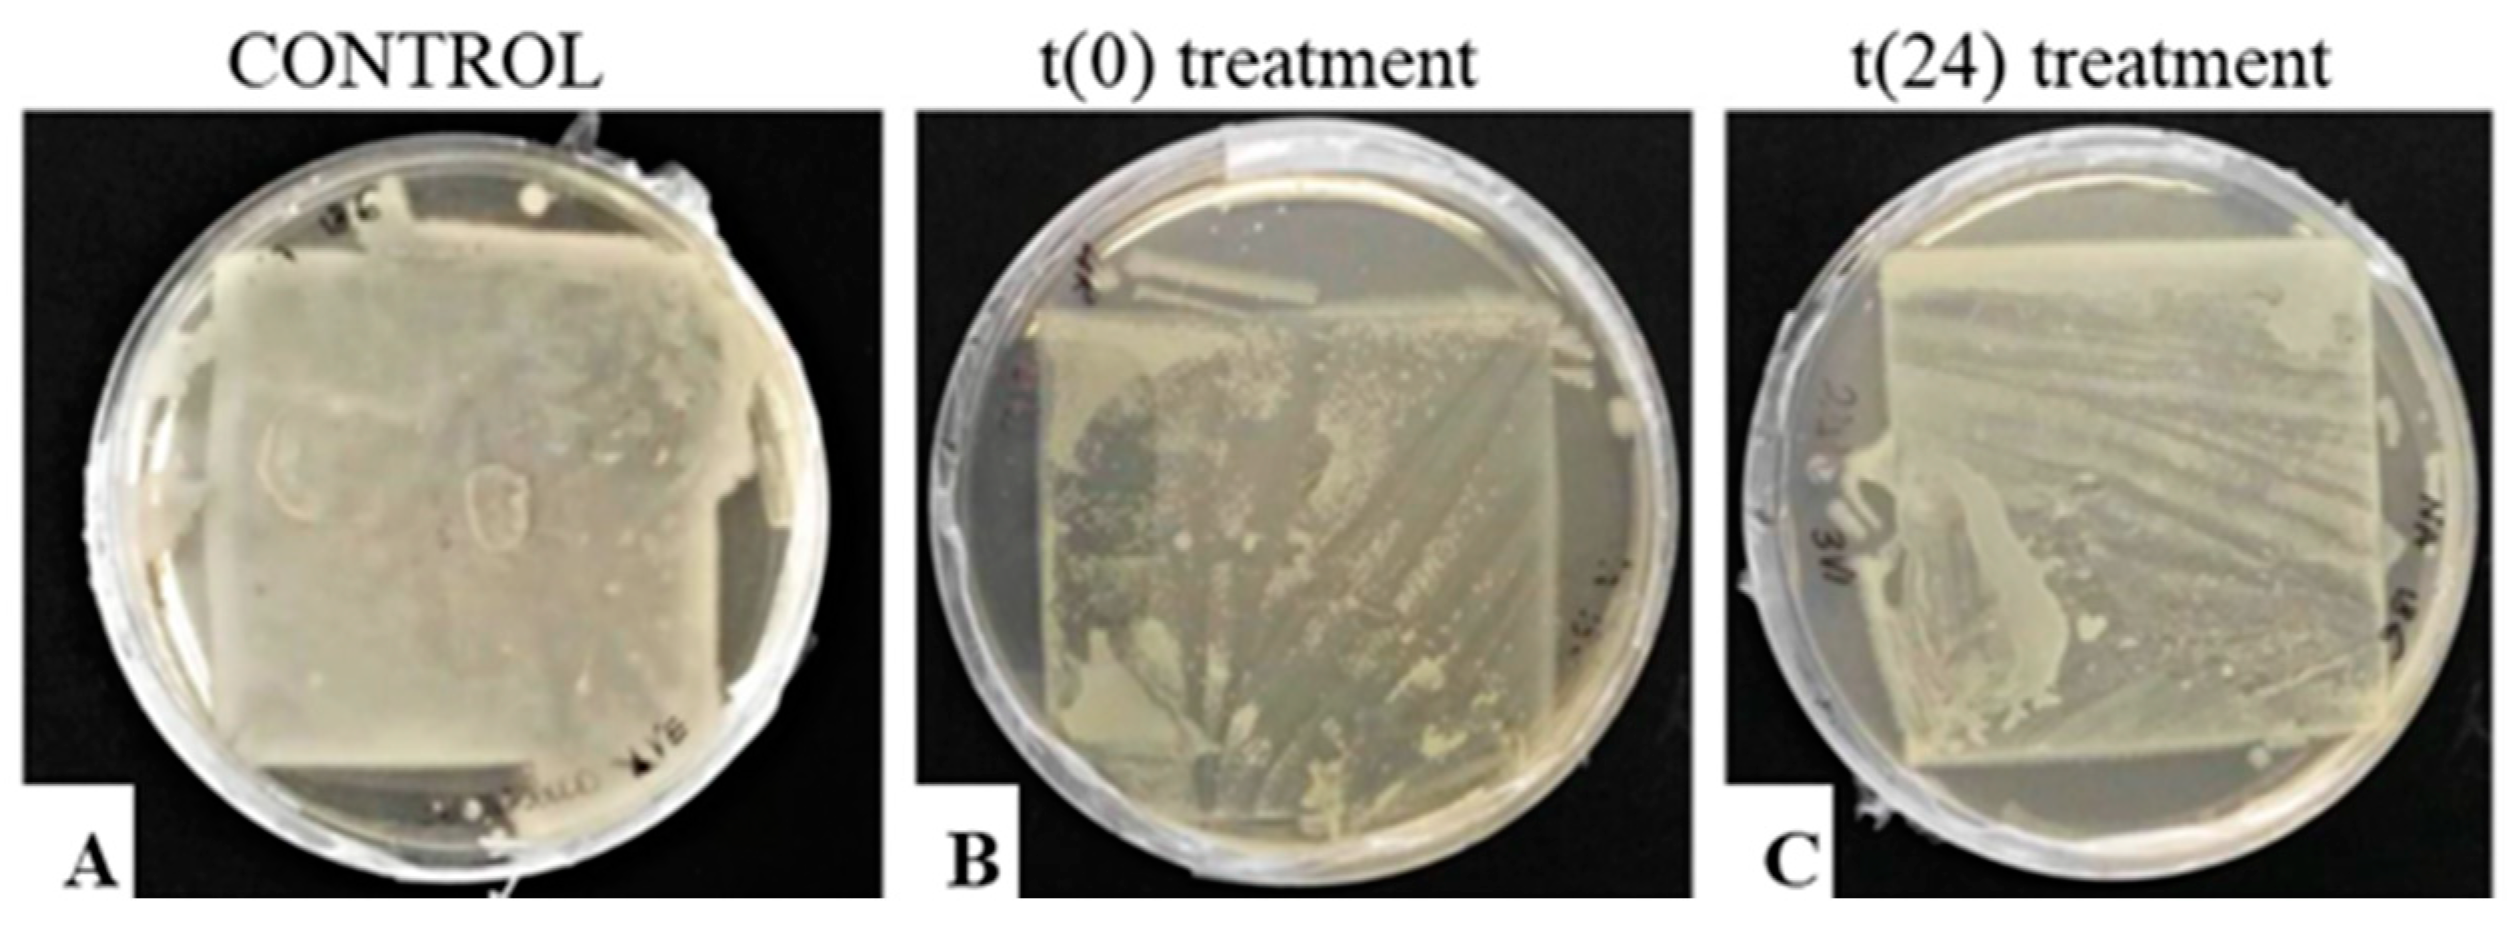

43 where should a label be written on an agar plate
2.1: Introduction - Biology LibreTexts Mar 19, 2021 ... 1. Always label your plates/tubes BEFORE you do your inoculations. You can use Sharpies on the plates, but wax markers ONLY on tubes. When ... Lab 9 & 10 Flashcards - Quizlet Labels should be written on the bottom of the agar plate.
Solved Why is it important to label the bottom of the agar | Chegg.com Question: Why is it important to label the bottom of the agar plate (the side with the agar) and NOT the lid of the plate? If you label the lid of the plate and ...

Where should a label be written on an agar plate
Proper method to label a petri plate prior to pour plating/inoculation Proper method to label a petri plate prior to pour plating/inoculation, with initials, date, ... A) Use the word inoculate in a sentence that relates to ... - Numerade where should a label be written on an agar plate? why? Discussion. You must be signed in to discuss. Correct labelling of agar plates in microbiology - YouTube May 28, 2019 ... Welcome to our suite of NUI Galway Microbiology teaching videos. We hope that they will guide you in performing your experiments in a ...
Where should a label be written on an agar plate. › drugs › guidances-drugsQuestions and Answers on Current Good Manufacturing Practice Sep 15, 2022 · Any status label should be correct, legible, readily visible, and associated with the correct piece of equipment. ... (e.g., blood agar) and nonselective (e.g., TSB and tryptic soy agar) media ... 2.2: Introduction to Bacterial Growth and Aseptic Techniques May 26, 2021 ... 1. Always label your plates/tubes BEFORE you do your inoculations. You can use Sharpies on the plates, but wax markers ONLY on tubes. When ... Aseptic Laboratory Techniques: Plating Methods - PMC - NCBI May 11, 2012 ... Label around the edge of the bottom (not the lid) of an agar plate with at least your name, the date, the type of growth medium, ... veux-veux-pas.fr › en › classified-adsAll classifieds - Veux-Veux-Pas, free classified ads Website All classifieds - Veux-Veux-Pas, free classified ads Website. Come and visit our site, already thousands of classified ads await you ... What are you waiting for? It's easy to use, no lengthy sign-ups, and 100% free!
learning-center.homesciencetools.com › articleHow to Grow Bacteria: 5 Experiments to Grow & Test Bacteria Slide open the cover of the petri dish just enough to pour agar into the dish. Pour enough agar to cover 1/2 to 2/3 of the bottom of the dish (about 10-13ml). Don’t let the bottle mouth touch the dish. Cover the dish immediately to prevent contamination and tilt it back and forth gently until the agar coats the entire bottom of the dish. microbeonline.com › cled-agar-composition-usesCLED Agar: Composition, Uses, Colony Characteristics Oct 06, 2022 · Quality Control of CLED Agar. QC of CLED agar should be done by performing sterility testing and performance testing. Sterility testing: Incubate 3-5 plates of uninoculated medium at 37℃ for 18-24 hrs. Any growth in the medium should be regarded positive and the whole lot should be discarded. microbeonline.com › macconkey-agar-mac-compositionMacConkey Agar: Composition, Uses, Colony Characteristics Jun 29, 2022 · After 48 hours, the sterility test plate should remain clear. Discard the whole lot if any colonies are seen. Performance testing: Inoculate known standard strains on MacConkey agar plates, incubate for 18-24 hours at 35-37°C, and observe for growth and colony characteristics. api.artic.edu › docsDocumentation | Art Institute of Chicago API The Art Institute of Chicago's API provides JSON formatted data as a REST-style service that allows developers to explore and integrate the museum’s data into their projects.
Q 9 2 Pts Where should a label be written on an agar plate Why The ... The label should be written on the bottom of the agar plate and not on the lid because when the agar plate is being stored / incubated , it is stored upside ... microbeonline.com › blood-agar-compositionBlood Agar and Types of Hemolysis – Microbe Online Oct 07, 2022 · Blood agar consists of a base containing a protein source (e.g. tryptones), soybean protein digest, sodium chloride (NaCl), agar, and 5% sheep blood.. Blood contains inhibitors for certain bacteria such as Neisseria and Haemophilus genera so the blood agar must be heated to inactivate these inhibitors and to release essential growth factors (e.g., V factor). Where should a label be written on an agar plate? - EssayGroom Before Labeling, sceptic procedure must be carried out to prevent contamination. A petri dish can be used for culture. An agar plate is a petri dish that ... Correct labelling of agar plates in microbiology - YouTube May 28, 2019 ... Welcome to our suite of NUI Galway Microbiology teaching videos. We hope that they will guide you in performing your experiments in a ...
A) Use the word inoculate in a sentence that relates to ... - Numerade where should a label be written on an agar plate? why? Discussion. You must be signed in to discuss.
Proper method to label a petri plate prior to pour plating/inoculation Proper method to label a petri plate prior to pour plating/inoculation, with initials, date, ...

Post a Comment for "43 where should a label be written on an agar plate"